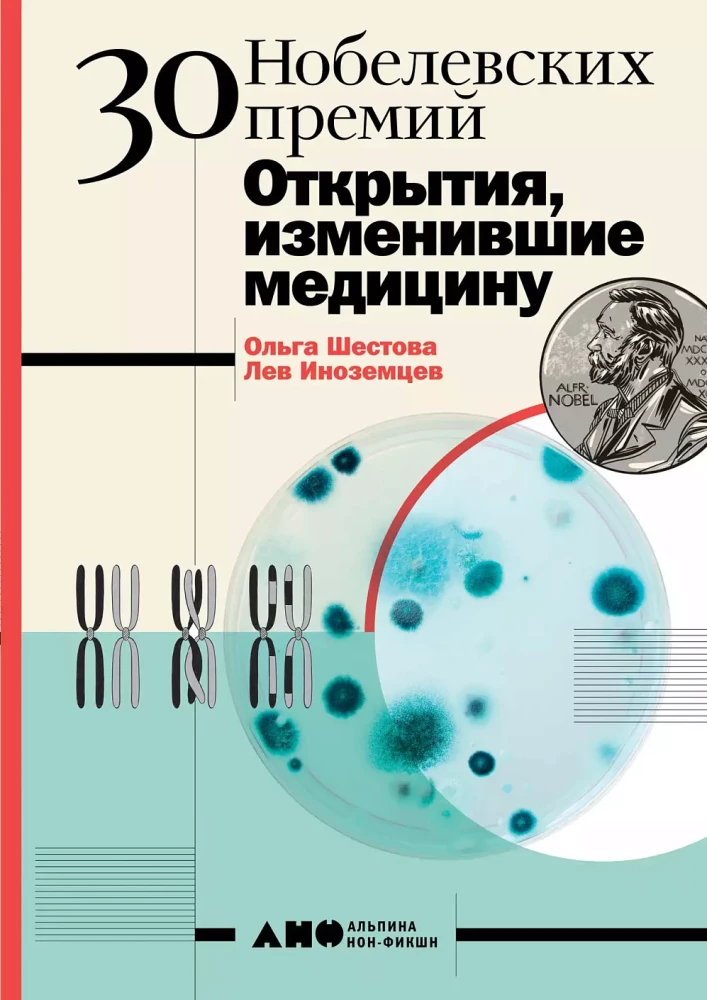
30 Nobelio premijų: Atradimai, pakeitę mediciną
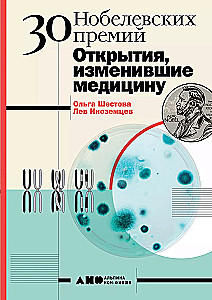
30 Nobelio premijų: Atradimai, pakeitę mediciną

30 Nobelio premijų: Atradimai, pakeitę mediciną
Autorius: Olga Šestova, Lev Inozemcev
Publisher: Al'pina Pablisher
Serija: Mokslas apie sveikatą
Amžiaus ribos: 12+
Išleidimo metai: 2023
ISBN: 9785001391814
Puslapių skaičius: 214
Dydis: 215h153h16 mm
Viršelio tipas: Hard
Svoris: 370 g
ID: 567172